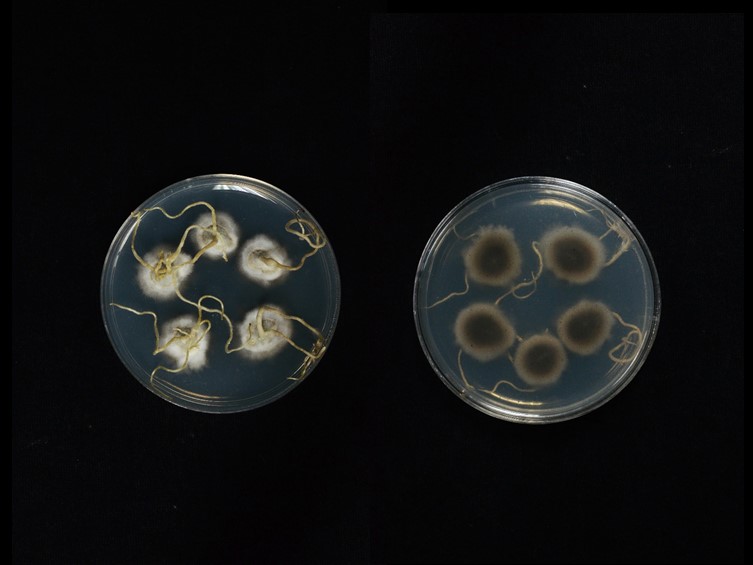

Holotype:
THAILAND, Nakhon Phanom Province, Pla Pak District, 22 Jul. 2020, A. Khonsanit, S. Sommai, U. Pinruan, holotype BBH 49127, ex-type living culture BCC 93023.
Habitat:
Buried in soil.
Host:
On Termites.
Description:

Stromata solitary, simple, cylindrical, up to 8 cm long, 1–2 mm wide, brown, ca. 4 cm deep buried under the soil. The fungal stroma emerging from the segment between the prothorax and mesothorax of one of the termite pairs. Fertile part distinctly subterminal with asexual morph at the apex, ca. 2 cm long, 2 mm wide. Asexual morph (Hirsutella-like) produced ca. 2.5 cm at the terminal part of the stroma, light brown to grey. 
Phialides arising from the hyphae along the terminal part of the stroma, 4–11 × 3–5 μm. 
Conidia hyaline, globose, 2–4 μm. Sexual morph: 
Perithecia pseudo-immersed, ovoid, covering middle part of stroma, 190–245 × 120–190 μm. 
Asci 8–spored, hyaline, filiform, 100–157 × 7–13 μm with ascus caps, 4–5 × 4.5–5.5 μm. 
Ascospores whole, hyaline, filiform with septa, 58–118 × 2–3 μm.
Culture characteristics:
Colonies on PDA attaining a diam of 10 mm in 20 d at 25 °C, yellowish grey to greyish yellow green, reverse dark greyish yellowish brown. 
Conidiogenous cells monophialidic to polyphialidic, arising singly from hyphae laterally, with an inflated base, 9–15 × 3–5 μm. 
Conidia hyaline, smooth, globose, arising from the apex of the neck, one celled, 2–4 μm.
Reference:
Tasanathai K, Khonsanit A, Noisripoom W, et al. (2022). Hidden species behind Ophiocordyceps (Ophiocordycipitaceae, Hypocreales) on termites: four new species from Thailand. Mycological Progress 21: 86.
DOI: https://doi.org/10.1007/s11557-022-01837-6Species |
Strain |
Compound |
Pubchem CID |
Biological activity |
Reference |
|---|
|
Strain |
MZ676740 |
|---|---|
| BCC 93023 | MZ675419 |